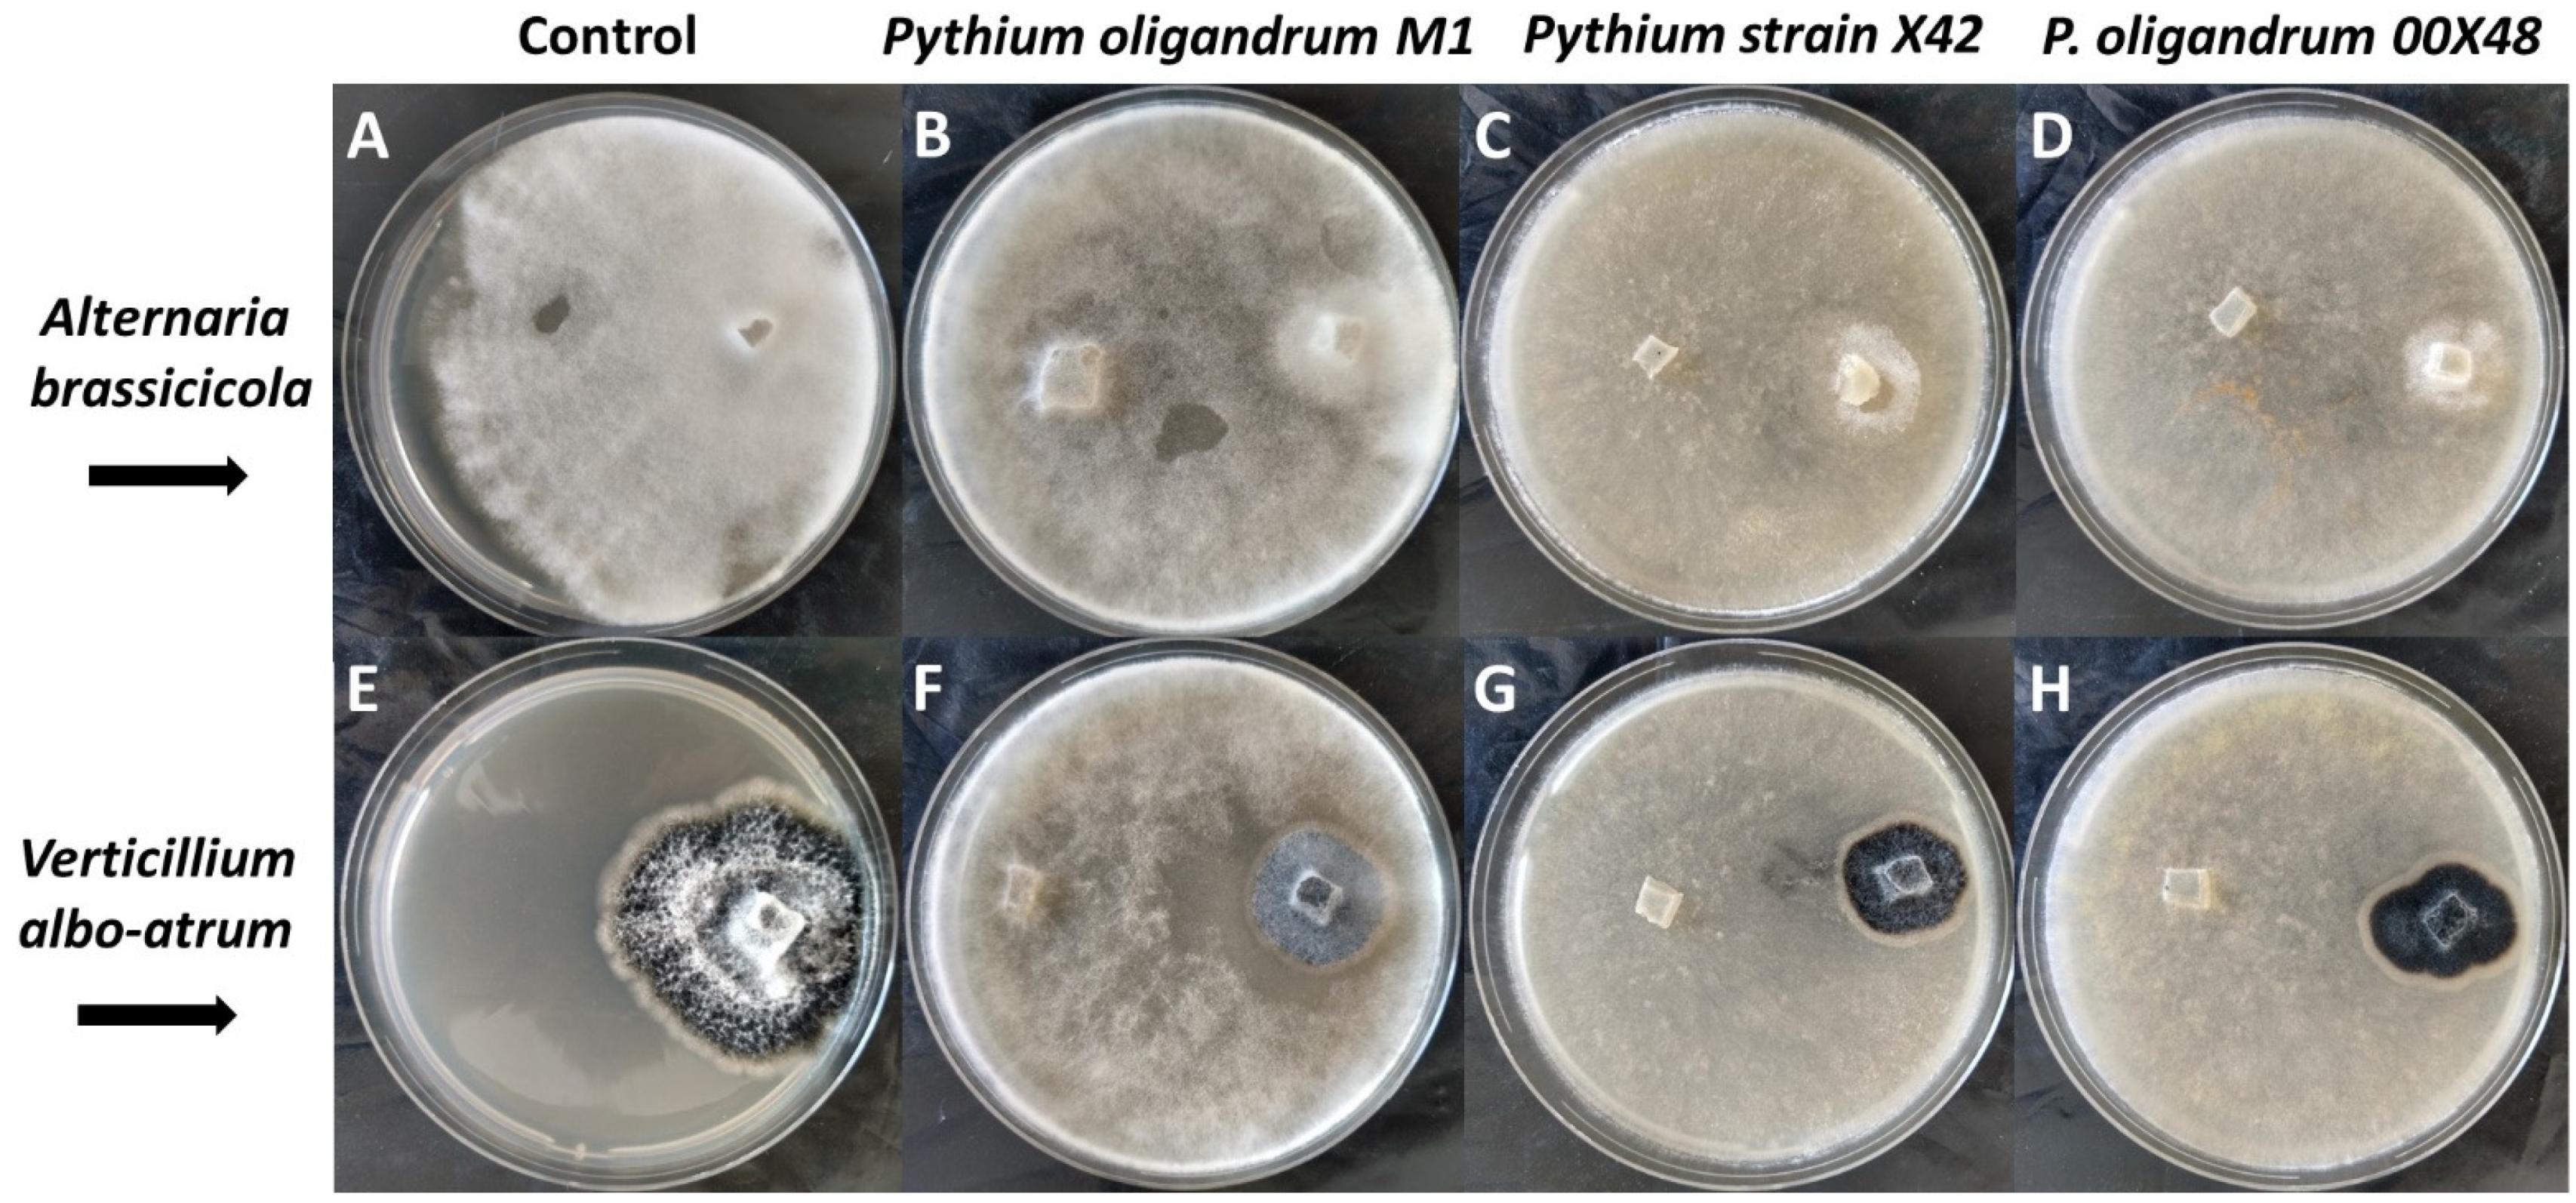
Microorganisms 10 01348 g002 Microorganisms 10 01348 g002

Seed Protection of Solanum lycopersicum with Pythium oligandrum against Alternaria brassicicola and Verticillium albo-atrum
Abstract
1. Introduction
2. Materials and Methods
2.1. In Vitro Dual Culture Tests of Pythium Strains against A. brassicicola/V. albo-atrum
2.2. Plant Material
2.3. Detection and Quantification of A. brassicicola and V. albo-atrum by qRT-PCR
2.4. Protein Concentration
2.5. Determination of Free Amino Acids and Tryptamine
2.6. Phenolics and Antioxidant Capacity
2.7. Enzyme Activity
2.8. Immunochemical Methods
2.9. Statistical Analysis
3. Results
3.1. Interactions between Pythium Strains and Fungal Phytopathogens
3.2. Seed-Coated Tomato Plants with Pythium Strains Exposed to Fungal Pathogens
3.3. Stress Conditions Affect Plant Metabolism
4. Discussion
5. Conclusions
Supplementary Materials
Author Contributions
Funding
Data Availability Statement
Acknowledgments
Conflicts of Interest
References
- Ons, L.; Bylemans, D.; Thevissen, K.; Cammue, B.P.A. Combining biocontrol agents with chemical fungicides for integrated plant fungal disease control. Microorganisms 2020, 8, 1930. [Google Scholar] [CrossRef] [PubMed]
- Mandelc, S.; Javornik, B. The secretome of vascular wilt pathogen Verticillium albo-atrum in simulated xylem fluid. Proteomics 2015, 15, 787–797. [Google Scholar] [CrossRef] [PubMed]
- Barrit, T.; Porcher, A.; Cukier, C.; Satour, P.; Guillemette, T.; Limami, A.M.; Teulat, B.; Campion, C.; Planchet, E. Nitrogen nutrition modifies the susceptibility of Arabidopsis thaliana to the necrotrophic fungus, Alternaria brassicicola. Physiol. Plant. 2021, 174, e13621. [Google Scholar] [CrossRef]
- Tralamazza, S.M.; Piacentini, K.C.; Iwase, C.H.T.; Rocha, L.D. Toxigenic Alternaria species: Impact in cereals worldwide. Curr. Opin. Food Sci. 2018, 23, 57–63. [Google Scholar] [CrossRef]
- Belonoznikova, K.; Hyskova, V.; Chmelik, J.; Kavan, D.; Cerovska, N.; Ryslava, H. Pythium oligandrum in plant protection and growth promotion: Secretion of hydrolytic enzymes, elicitors and tryptamine as auxin precursor. Microbiol. Res. 2022, 258, 126976. [Google Scholar] [CrossRef]
- Benhamou, N.; le Floch, G.; Vallance, J.; Gerbore, J.; Grizard, D.; Rey, P. Pythium oligandrum: An example of opportunistic success. Microbiology 2012, 158, 2679–2694. [Google Scholar] [CrossRef]
- Gerbore, J.; Benhamou, N.; Vallance, J.; Le Floch, G.; Grizard, D.; Regnault-Roger, C.; Rey, P. Biological control of plant pathogens: Advantages and limitations seen through the case study of Pythium oligandrum. Environ. Sci. Pollut. Res. Int. 2014, 21, 4847–4860. [Google Scholar] [CrossRef]
- McGowan, J.; Fitzpatrick, D.A. Genomic, network, and phylogenetic analysis of the oomycete effector arsenal. mSphere 2017, 2, e00408-17. [Google Scholar] [CrossRef]
- Derevnina, L.; Dagdas, Y.F.; De la Concepcion, J.C.; Bialas, A.; Kellner, R.; Petre, B.; Domazakis, E.; Du, J.; Wu, C.H.; Lin, X.; et al. Nine things to know about elicitins. New Phytol. 2016, 212, 888–895. [Google Scholar] [CrossRef]
- Takenaka, S.; Nishio, Z.; Nakamura, Y. Induction of defense reactions in sugar beet and wheat by treatment with cell wall protein fractions from the mycoparasite Pythium oligandrum. Phytopathology 2003, 93, 1228–1232. [Google Scholar] [CrossRef]
- Takenaka, S.; Tamagake, H. Foliar spray of a cell wall protein fraction from the biocontrol agent Pythium oligandrum induces defence-related genes and increases resistance against Cercospora leaf spot in sugar beet. J. Gen. Plant Pathol. 2009, 75, 340–348. [Google Scholar] [CrossRef]
- Takenaka, S.; Yamaguchi, K.; Masunaka, A.; Hase, S.; Inoue, T.; Takahashi, H. Implications of oligomeric forms of POD-1 and POD-2 proteins isolated from cell walls of the biocontrol agent Pythium oligandrum in relation to their ability to induce defense reactions in tomato. J. Plant Physiol. 2011, 168, 1972–1979. [Google Scholar] [CrossRef] [PubMed]
- Ai, G.; Yang, K.; Tian, Y.; Ye, W.; Tian, Y.; Du, Y.; Zhu, H.; Li, T.; Xia, Q.; Shen, D.; et al. Prediction and characterization of RXLR effectors in Pythium species. Mol. Plant Microbe Interact. 2019, 33, 1046–1058. [Google Scholar] [CrossRef] [PubMed]
- Yang, K.; Dong, X.; Li, J.; Wang, Y.; Cheng, Y.; Zhai, Y.; Li, X.; Wei, L.; Jing, M.; Dou, D. Type 2 Nep1-like proteins from the biocontrol oomycete Pythium oligandrum suppress Phytophthora capsici infection in Solanaceous plants. J. Fungi 2021, 7, 496. [Google Scholar] [CrossRef] [PubMed]
- Hase, S.; Shimizu, A.; Nakaho, K.; Takenaka, S.; Takahashi, H. Induction of transient ethylene and reduction in severity of tomato bacterial wilt by Pythium oligandrum. Plant Pathol. 2006, 55, 537–543. [Google Scholar] [CrossRef]
- Hase, S.; Takahashi, S.; Takenaka, S.; Nakaho, K.; Arie, T.; Seo, S.; Ohashi, Y.; Takahashi, H. Involvement of jasmonic acid signalling in bacterial wilt disease resistance induced by biocontrol agent Pythium oligandrum in tomato. Plant Pathol. 2008, 57, 870–876. [Google Scholar] [CrossRef]
- Lou, B.-G.; Wang, A.-Y.; Lin, C.; Xu, T.; Zheng, X.-D. Enhancement of defense responses by oligandrin against Botrytis cinerea in tomatoes. Afr. J. Biotechnol. 2011, 10, 11442–11449. [Google Scholar] [CrossRef]
- Takenaka, S. Studies on biological control mechanisms of Pythium oligandrum. J. Gen. Plant Pathol. 2015, 81, 466–469. [Google Scholar] [CrossRef]
- Le Floch, G.; Rey, P.; Benizri, E.; Benhamou, N.; Tirilly, Y. Impact of auxin-compounds produced by the antagonistic fungus Pythium oligandrum or the minor pathogen Pythium group F on plant growth. Plant Soil 2003, 257, 459–470. [Google Scholar] [CrossRef]
- Doubnerova, V.; Ryslava, H. Roles of Hsp70 in plant abiotic stress. In Molecular Approaches in Plant Abiotic Stress; Gaur, R.K., Sharma, P., Eds.; CRC Press: Boca Raton, FL, USA, 2014; pp. 44–66. [Google Scholar]
- Song, Z.; Pan, F.; Lou, X.; Wang, D.; Yang, C.; Zhang, B.; Zhang, H. Genome-wide identification and characterization of Hsp70 gene family in Nicotiana tabacum. Mol. Biol. Rep. 2019, 46, 1941–1954. [Google Scholar] [CrossRef]
- Sappah, A.E.; Abbas, M.; Elrys, A.S.; Yadav, V.; El-Sappah, H.H.; Zhu, Y.; Huang, Q.; Yu, W.; Soaud, S.A.E.; Xianming, Z.; et al. The Hsp70 gene family in Solanum lycopersicum; Genome-wide identification and expression analysis under heavy metals stresses. Res. Sq. 2021, in press. [Google Scholar] [CrossRef]
- Zai, W.S.; Miao, L.X.; Xiong, Z.L.; Zhang, H.L.; Ma, Y.R.; Li, Y.L.; Chen, Y.B.; Ye, S.G. Comprehensive identification and expression analysis of Hsp90s gene family in Solanum lycopersicum. Genet. Mol. Res. 2015, 14, 7811–7820. [Google Scholar] [CrossRef] [PubMed]
- Belonoznikova, K.; Vaverova, K.; Vanek, T.; Kolarik, M.; Hyskova, V.; Vankova, R.; Dobrev, P.; Krizek, T.; Hodek, O.; Cokrtova, K.; et al. Novel insights into the effect of Pythium strains on rapeseed metabolism. Microorganisms 2020, 8, 1472. [Google Scholar] [CrossRef] [PubMed]
- Fradin, E.F.; Thomma, B.P.H.J. Physiology and molecular aspects of Verticillium wilt diseases caused by V. dahliae and V. albo-atrum. Mol. Plant Pathol. 2006, 7, 71–86. [Google Scholar] [CrossRef]
- Sirima, A.; Sereme, A.; Koita, K.; Zida, E.; Nana, A.T.; Sereme, D.; Nana, T.; Sawadogo, M. Characterization of Alternaria brassicicola isolated from tomato in Burkina Faso, and use of two essential oils for its control in vitro. Afr. J. Agric. Res. 2021, 17, 1371–1379. [Google Scholar] [CrossRef]
- Hajieghrari, B.; Torabi-Giglou, M.; Mohammadi, M.R.; Davari, M. Biological potantial of some Iranian Trichoderma isolates in the control of soil borne plant pathogenic fungi. Afr. J. Biotechnol. 2008, 7, 967–972. [Google Scholar]
- Bradford, M.M. A rapid and sensitive method for the quantitation of microgram quantities of protein utilizing the principle of protein-dye binding. Anal. Biochem. 1976, 72, 248–254. [Google Scholar] [CrossRef]
- Hodek, O.; Krizek, T.; Coufal, P.; Ryslava, H. Design of experiments for amino acid extraction from tobacco leaves and their subsequent determination by capillary zone electrophoresis. Anal. Bioanal. Chem. 2017, 409, 2383–2391. [Google Scholar] [CrossRef]
- Mittler, R.; Zilinskas, B.A. Detection of ascorbate peroxidase-activity in native gels by inhibition of the ascorbate-dependent reduction of nitroblue tetrazolium. Anal. Biochem. 1993, 212, 540–546. [Google Scholar] [CrossRef]
- Ricci, G.; Lobello, M.; Caccuri, A.M.; Galiazzo, F.; Federici, G. Detection of glutathione transferase activity on polyacrylamide gels. Anal. Biochem. 1984, 143, 226–230. [Google Scholar] [CrossRef]
- Laemmli, U.K. Cleavage of structural proteins during assembly of head of bacteriophage-T4. Nature 1970, 227, 680–685. [Google Scholar] [CrossRef]
- Hyskova, V.; Pliskova, V.; Cerveny, V.; Ryslava, H. NADP-dependent enzymes are involved in response to salt and hypoosmotic stress in cucumber plants. Gen. Physiol. Biophys. 2017, 36, 247–258. [Google Scholar] [CrossRef] [PubMed]
- Iven, T.; Konig, S.; Singh, S.; Braus-Stromeyer, S.A.; Bischoff, M.; Tietze, L.F.; Braus, G.H.; Lipka, V.; Feussner, I.; Droge-Laser, W. Transcriptional activation and production of tryptophan-derived secondary metabolites in Arabidopsis roots contributes to the defense against the fungal vascular pathogen Verticillium longisporum. Mol. Plant 2012, 5, 1389–1402. [Google Scholar] [CrossRef] [PubMed]
- Pavlikova, D.; Zemanova, V.; Prochazkova, D.; Pavlik, M.; Szakova, J.; Wilhelmova, N. The long-term effect of zinc soil contamination on selected free amino acids playing an important role in plant adaptation to stress and senescence. Ecotoxicol. Environ. Saf. 2014, 100, 166–170. [Google Scholar] [CrossRef] [PubMed]
- Dulermo, T.; Bligny, R.; Gout, E.; Cotton, P. Amino acid changes during sunflower infection by the necrotrophic fungus B. cinerea. Plant Signal. Behav. 2009, 4, 859–861. [Google Scholar] [CrossRef]
- Jez, J.M. Structural biology of plant sulfur metabolism: From sulfate to glutathione. J. Exp. Bot. 2019, 70, 4089–4103. [Google Scholar] [CrossRef]
- Zeier, J. New insights into the regulation of plant immunity by amino acid metabolic pathways. Plant Cell Environ. 2013, 36, 2085–2103. [Google Scholar] [CrossRef]
- Ali, S.; Ganai, B.A.; Kamili, A.N.; Bhat, A.A.; Mir, Z.A.; Bhat, J.A.; Tyagi, A.; Islam, S.T.; Mushtaq, M.; Yadav, P.; et al. Pathogenesis-related proteins and peptides as promising tools for engineering plants with multiple stress tolerance. Microbiol. Res. 2018, 212, 29–37. [Google Scholar] [CrossRef]
- Satkova, P.; Stary, T.; Pleskova, V.; Zapletalova, M.; Kasparovsky, T.; Cincalova-Kubienova, L.; Luhova, L.; Mieslerova, B.; Mikulik, J.; Lochman, J.; et al. Diverse responses of wild and cultivated tomato to BABA, oligandrin and Oidium neolycopersici infection. Ann. Bot. 2017, 119, 829–840. [Google Scholar] [CrossRef][Green Version]
- Berka, M.; Kopecka, R.; Berkova, V.; Brzobohaty, B.; Cerny, M. Regulation of heat shock proteins 70 and their role in plant immunity. J. Exp. Bot. 2022, 73, 1894–1909. [Google Scholar] [CrossRef]
- Lee, J.H.; Yun, H.S.; Kwon, C. Molecular communications between plant heat shock responses and disease resistance. Mol. Cells 2012, 34, 109–116. [Google Scholar] [CrossRef]
- Moshe, A.; Gorovits, R.; Liu, Y.; Czosnek, H. Tomato plant cell death induced by inhibition of HSP90 is alleviated by Tomato yellow leaf curl virus infection. Mol. Plant Pathol. 2016, 17, 247–260. [Google Scholar] [CrossRef] [PubMed]
- Hyskova, V.; Belonoznikova, K.; Doricova, V.; Kavan, D.; Gillarova, S.; Henke, S.; Synkova, H.; Ryslava, H.; Cerovska, N. Effects of heat treatment on metabolism of tobacco plants infected with Potato virus Y. Plant Biol. 2021, 23, 131–141. [Google Scholar] [CrossRef] [PubMed]

| C | M1 | X42 | 00X48 | A-C | A-M1 | A-X42 | A-00X48 | V-C | V-M1 | V-X42 | V-00X48 | |
|---|---|---|---|---|---|---|---|---|---|---|---|---|
| Alanine | 100 ± 5% | 114 ± 4% | 131 ± 17% | 112 ± 4% | 94 ± 5% | 105 ± 7% | 127% ± 1 * | 101 ± 1% | 80 ± 19% | 137 ± 15% | 145 ± 9% * | 119 ± 13% |
| Arginine | 100 ± 6% | 87 ± 9% | 132 ± 16% | 78 ± 2% | 84 ± 6% | 117 ± 12% | 108 ± 1% | 96 ± 11% | 29 ± 2% * | 69 ± 27% | 124 ± 9% | 118 ± 2% |
| Asparagine | 100 ± 13% | 113 ± 7% | 74 ± 5% | 187 ± 6% | 36 ± 3% * | 62 ± 6% | 73 ± 6% | 127 ± 2% * | 57 ± 1% * | 45 ± 3% * | 69 ± 7% | 53 ± 5% |
| Aspartate | 100 ± 0% | 108 ± 9% | 74 ± 16% | 100 ± 6% | 188 ± 17% * | 177 ± 12% * | 132 ± 9% * | 124 ± 5% * | 129 ± 14% | 149 ± 32% | 125 ± 18% | 124 ± 10% * |
| Cysteine | <LOD | <LOD | <LOD | <LOD | <LOD | <LOD | <LOD | <LOD | <LOD | <LOD | <LOD | <LOD |
| Glutamine | 100 ± 5% | 107 ± 6% | 72 ± 11% | 156 ± 5% | 60 ± 6% * | 95 ± 6% | 72 ± 3% * | 127 ± 0% * | 59 ± 6% * | 80 ± 14% | 78 ± 6% * | 63 ± 4% * |
| Glutamate | 100 ± 1% | 4 ± 0% * | 48 ± 4% * | 67 ± 5% * | 168 ± 16% * | 6 ± 0% * | 19 ± 8% * | 43 ± 3% * | 331 ± 34% * | 163 ± 26% | 8 ± 1% * | 174 ± 5% * |
| Glycine | 100 ± 4% | 45 ± 16% | 165 ± 30% | 57 ± 7% | 25 ± 10% * | 55 ± 4% * | 104 ± 9% | 72 ± 11% | 38 ± 17% * | 65 ± 35% | 73 ± 3% * | 98 ± 21% |
| Histidine | 100 ± 8% | 100 ± 6% | 114 ± 16% | 58 ± 3% | 31 ± 3% * | 58 ± 8% * | 86 ± 10% | 65 ± 6% * | 25 ± 0% * | 54 ± 16% | 75 ± 10% | 66 ± 7% |
| Isoleucine | 100 ± 2% | 81 ± 7% | 128 ± 17% | 67 ± 6% | 59 ± 5% * | 70 ± 4% * | 99 ± 3% | 74 ± 9% | 49 ± 13% * | 76 ± 14% | 102 ± 11% | 97 ± 11% |
| Leucine | 100 ± 2% | 88 ± 2% * | 134 ± 4% * | 70 ± 3% * | 71 ± 12% | 79 ± 5% * | 112 ± 4% | 80 ± 2% * | 45 ± 8% * | 84 ± 10% | 116 ± 6% | 109 ± 3% |
| Lysine | 100 ± 1% | 94 ± 8% | 147 ± 16% | 92 ± 2% | 86 ± 8% | 89 ± 8% | 130 ± 3% * | 96 ± 2% | 59 ± 7% * | 87 ± 25% | 117 ± 7% | 119 ± 5% * |
| Methionine | 100 ± 4% | 199 ± 30% | 555 ± 91% * | 45 ± 5% * | <LOD * | 69 ± 4% * | 63 ± 5% * | 111 ± 16% | 126 ± 14% | 0 ± 0% * | 215 ± 59% | 230 ± 20% * |
| Phenylalanine | 100 ± 9% | 103 ± 5% | 105 ± 14% | 90 ± 6% | 70 ± 11% | 92 ± 5% | 104 ± 11% | 111 ± 3% | 338 ± 49% * | 104 ± 14% | 103 ± 15% | 101 ± 9% |
| Proline | 100 ± 11% | 154 ± 15% | 158 ± 28% | 49 ± 4% | 50 ± 4% * | 79 ± 14% | 110 ± 11% | 92 ± 6% | 33 ± 2% * | 59 ± 2% | 97 ± 13% | 72 ± 14% |
| Serine | 100 ± 2% | 90 ± 10% | 100 ± 13% | 90 ± 0% | 75 ± 15% | 71 ± 2% * | 82 ± 4% * | 77 ± 3% * | 52 ± 10% * | 58 ± 10% * | 79 ± 4% * | 88 ± 8% |
| Threonine | 100 ± 2% | 111 ± 6% | 97 ± 8% | 94 ± 3% | 96 ± 14% | 97 ± 2% | 101 ± 6% | 90 ± 3% | 86 ± 1% * | 86 ± 27% | 128 ± 9% | 99 ± 2% |
| Tryptophan | 100 ± 3% | 104 ± 9% | 106 ± 6% | 24 ± 0% | 64 ± 3% * | 36 ± 6% * | 69 ± 3% * | 41 ± 5% * | 39 ± 1% * | 63 ± 25% | 48 ± 6% * | 41 ± 4% * |
| Tyrosine | 100 ± 5% | 99 ± 5% | 134 ± 0% | 83 ± 9% | 105 ± 10% | 85 ± 11% | 95 ± 4% | 90 ± 6% | 47 ± 4% * | 103 ± 17% | 91 ± 11% | 85 ± 17% |
| Valine | 100 ± 2% | 107 ± 4% | 133 ± 28% | 83 ± 5% | 83 ± 7% | 93 ± 3% | 115 ± 4% * | 84 ± 3% * | 71 ± 18% | 90 ± 5% | 132 ± 11% | 118 ± 7% |
| Figure | Determination | DF between Groups | DF—Residual | F-Value | p-Value |
|---|---|---|---|---|---|
| in vitro test | Alternaria brassicicola | 2 | 8 | 9.431 | 0.014 |
| Verticillium albo-atrum | 2 | 8 | 0.362 | 0.711 | |
| Figure 3 | pathogen content | 7 | 16 | 4.23 | 0.008 |
| protein content | 11 | 46 | 1.076 | 0.4 | |
| total aa content | 11 | 24 | 25.589 | <0.001 | |
| tryptamine content | 11 | 24 | 5.518 | <0.001 | |
| total phenolics | 11 | 36 | 3.851 | 0.001 | |
| antioxidant capacity | 11 | 36 | 2.447 | 0.021 | |
| Figure 4 | peroxidases/POD soluble—leaves | 11 | 24 | 4.138 | 0.002 |
| peroxidases/POD bound—leaves | 11 | 24 | 22.586 | <0.001 | |
| peroxidases/POD soluble—stems | 11 | 24 | 93.534 | <0.001 | |
| peroxidases/POD bound—stems | 11 | 24 | 861.548 | <0.001 | |
| ascorbate peroxidase/APOD—leaves | 11 | 24 | 0.886 | 0.566 | |
| ascorbate peroxidase/APOD—stems | 11 | 18 | 3.883 | 0.005 | |
| glutathione reductase/GR—leaves | 11 | 39 | 3.456 | 0.002 | |
| glutathione reductase/GR—stems | 11 | 12 | 7.614 | <0.001 | |
| Figure 6 | catalase/CAT | 11 | 46 | 14.398 | <0.001 |
| glucose-6-phosphate dehydrogenase/G6PDH | 11 | 36 | 3.725 | 0.001 | |
| malic enzyme/NADP-ME | 11 | 37 | 5.636 | <0.001 | |
| shikimate dehydrogenase/SDH | 11 | 47 | 5.94 | <0.001 | |
| Figure 7 | cellulase—leaves | 11 | 24 | 23.694 | <0.001 |
| chitinase—leaves | 11 | 24 | 32.412 | <0.001 | |
| endo-β-1,3-glucanase—leaves | 11 | 24 | 13.506 | <0.001 | |
| cellulase—stems | 11 | 24 | 115.718 | <0.001 | |
| chitinase—stems | 11 | 24 | 60.431 | <0.001 | |
| endo-β-1,3-glucanase—stems | 11 | 24 | 154.071 | <0.001 |
Publisher’s Note: MDPI stays neutral with regard to jurisdictional claims in published maps and institutional affiliations. |
© 2022 by the authors. Licensee MDPI, Basel, Switzerland. This article is an open access article distributed under the terms and conditions of the Creative Commons Attribution (CC BY) license (https://creativecommons.org/licenses/by/4.0/).
Share and Cite
Bělonožníková, K.; Hýsková, V.; Vašková, M.; Křížek, T.; Čokrtová, K.; Vaněk, T.; Halířová, L.; Chudý, M.; Žufić, A.; Ryšlavá, H. Seed Protection of Solanum lycopersicum with Pythium oligandrum against Alternaria brassicicola and Verticillium albo-atrum. Microorganisms 2022, 10, 1348. https://doi.org/10.3390/microorganisms10071348
Bělonožníková K, Hýsková V, Vašková M, Křížek T, Čokrtová K, Vaněk T, Halířová L, Chudý M, Žufić A, Ryšlavá H. Seed Protection of Solanum lycopersicum with Pythium oligandrum against Alternaria brassicicola and Verticillium albo-atrum. Microorganisms. 2022; 10(7):1348. https://doi.org/10.3390/microorganisms10071348
Chicago/Turabian StyleBělonožníková, Kateřina, Veronika Hýsková, Marie Vašková, Tomáš Křížek, Kateřina Čokrtová, Tomáš Vaněk, Lucie Halířová, Michal Chudý, Antoniana Žufić, and Helena Ryšlavá. 2022. "Seed Protection of Solanum lycopersicum with Pythium oligandrum against Alternaria brassicicola and Verticillium albo-atrum" Microorganisms 10, no. 7: 1348. https://doi.org/10.3390/microorganisms10071348
APA StyleBělonožníková, K., Hýsková, V., Vašková, M., Křížek, T., Čokrtová, K., Vaněk, T., Halířová, L., Chudý, M., Žufić, A., & Ryšlavá, H. (2022). Seed Protection of Solanum lycopersicum with Pythium oligandrum against Alternaria brassicicola and Verticillium albo-atrum. Microorganisms, 10(7), 1348. https://doi.org/10.3390/microorganisms10071348

